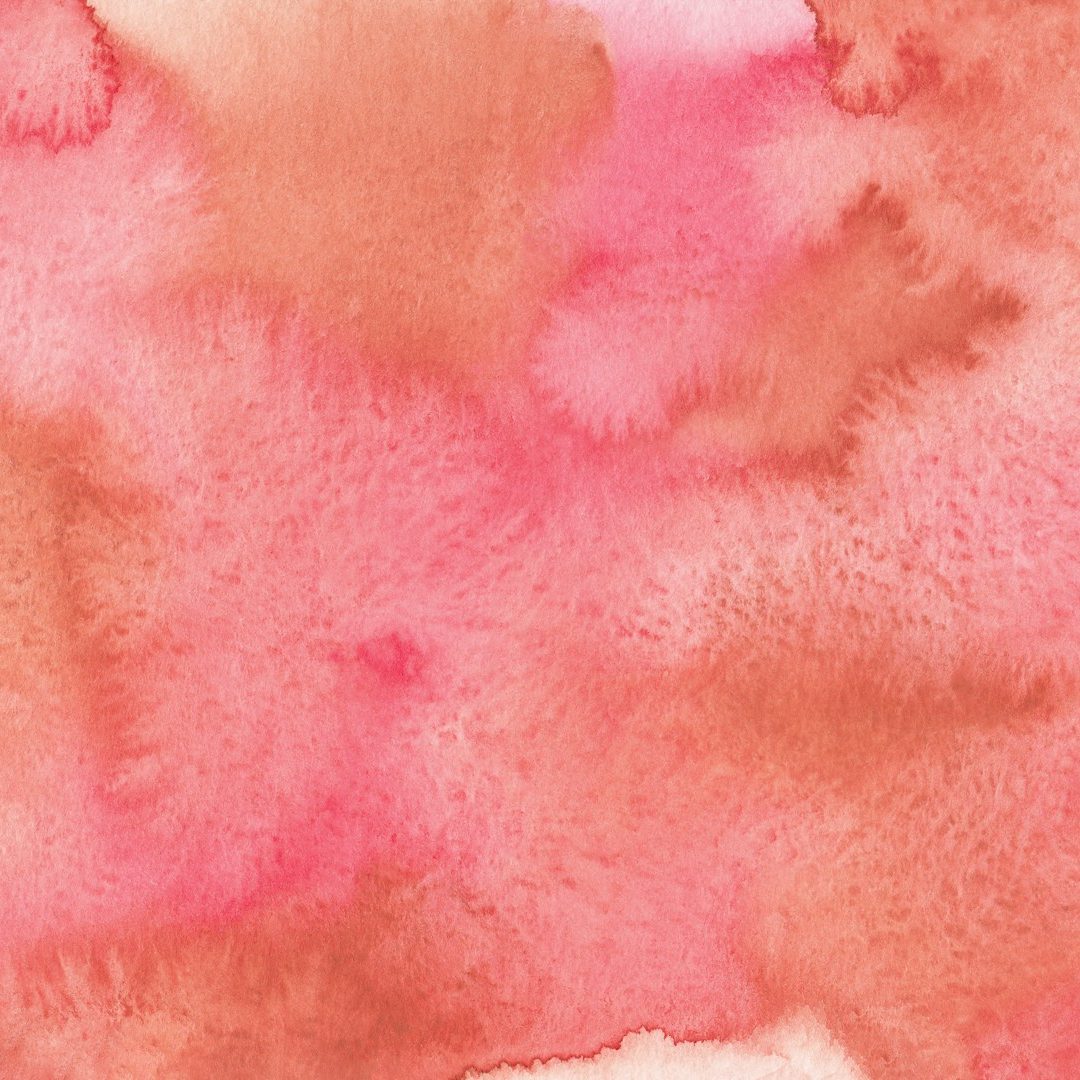

Arte personalizado con alma y creatividad
Cada obra AlbArt es única, creada cuidadosamente con técnicas de dibujo y acuarela adaptadas a tu estilo, perfecta para regalos especiales o decoración de hogar con personalidad.
Creatividad que transforma cada trazo
En AlbArt combinamos técnicas tradicionales de dibujo y acuarela para crear piezas totalmente personalizadas que reflejan la esencia de cada cliente. Nuestro compromiso es ofrecer arte original que convierte cada regalo o espacio en algo verdaderamente especial.

1.5k
Clientes satisfechos
350+
Obras personalizadas creadas
10+
Años de experiencia artística
Dibujos a mano alzada
Cada dibujo es realizado a mano asegurando exclusividad y detalle en cada línea y forma.
Técnicas de acuarela únicas
Aplicamos acuarelas con una creatividad que da vida y profundidad a cada obra personalizada.


Atención personalizada
Trabajamos contigo para que cada obra refleje tu visión y emociones, creando piezas originales y significativas.
Ideal para regalos y decoración
Nuestras obras son perfectas para sorprender con un regalo único o para dar personalidad a tu hogar.

